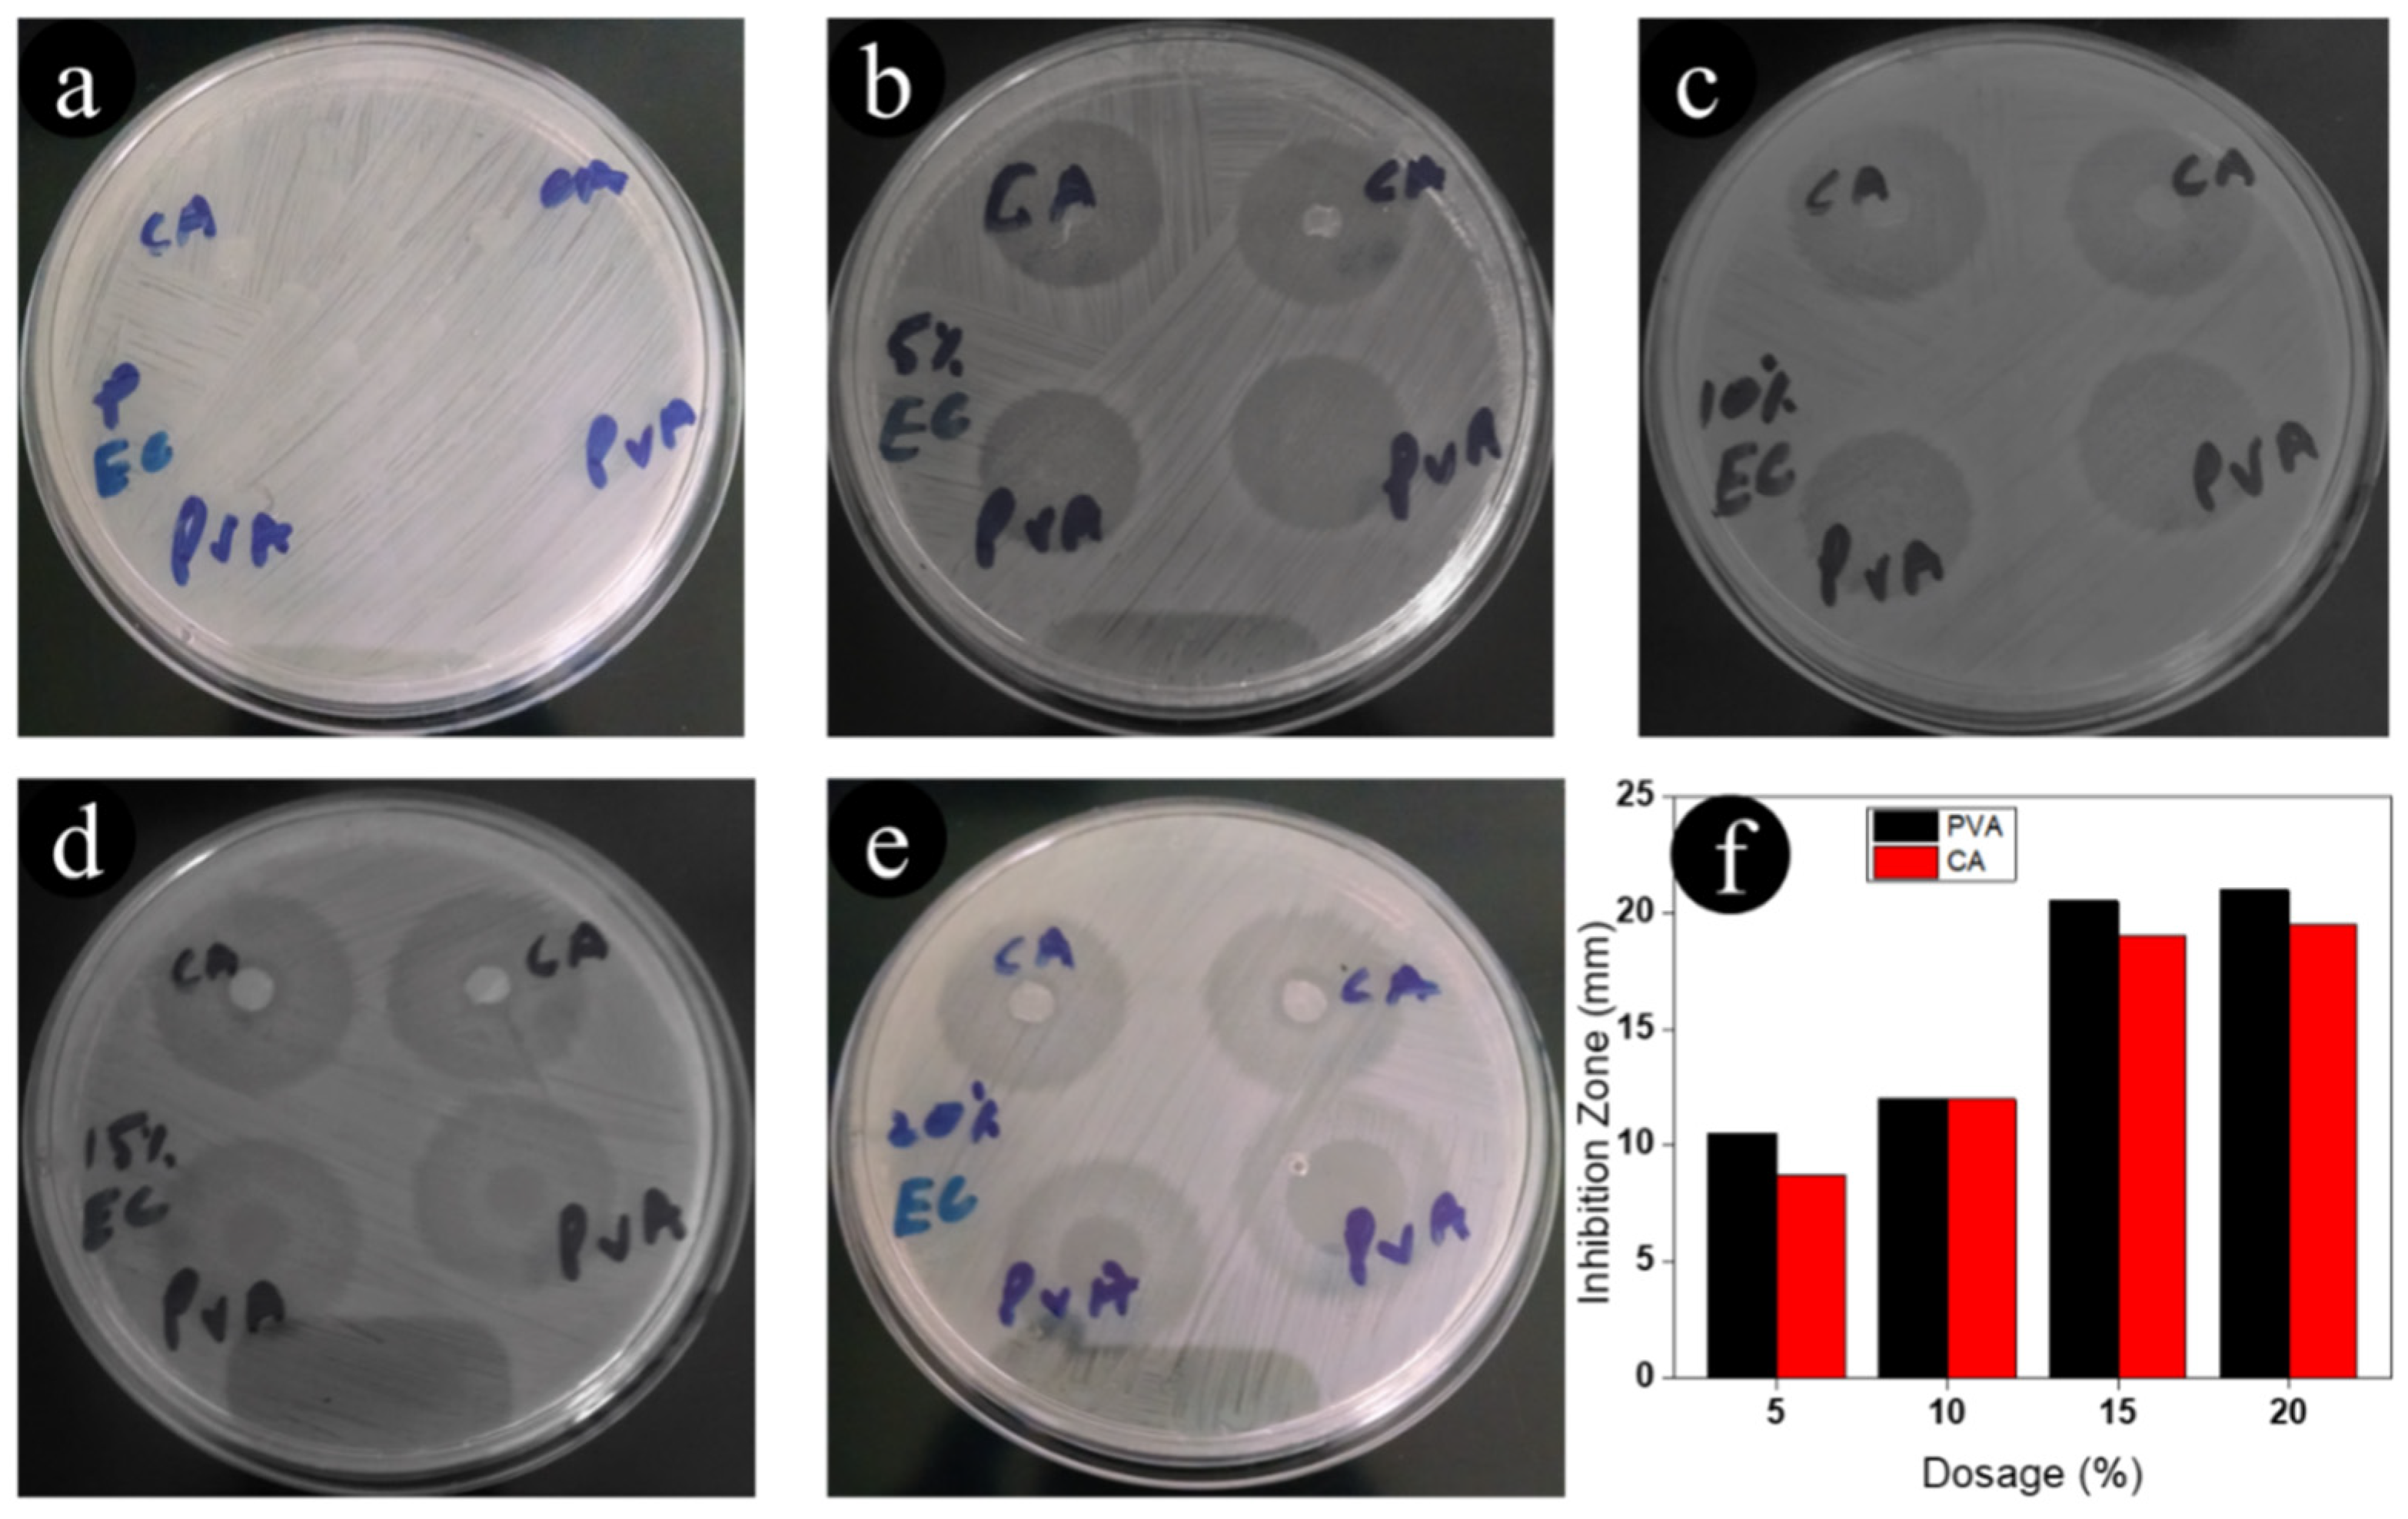
Antibiotics 11 00352 g004 550
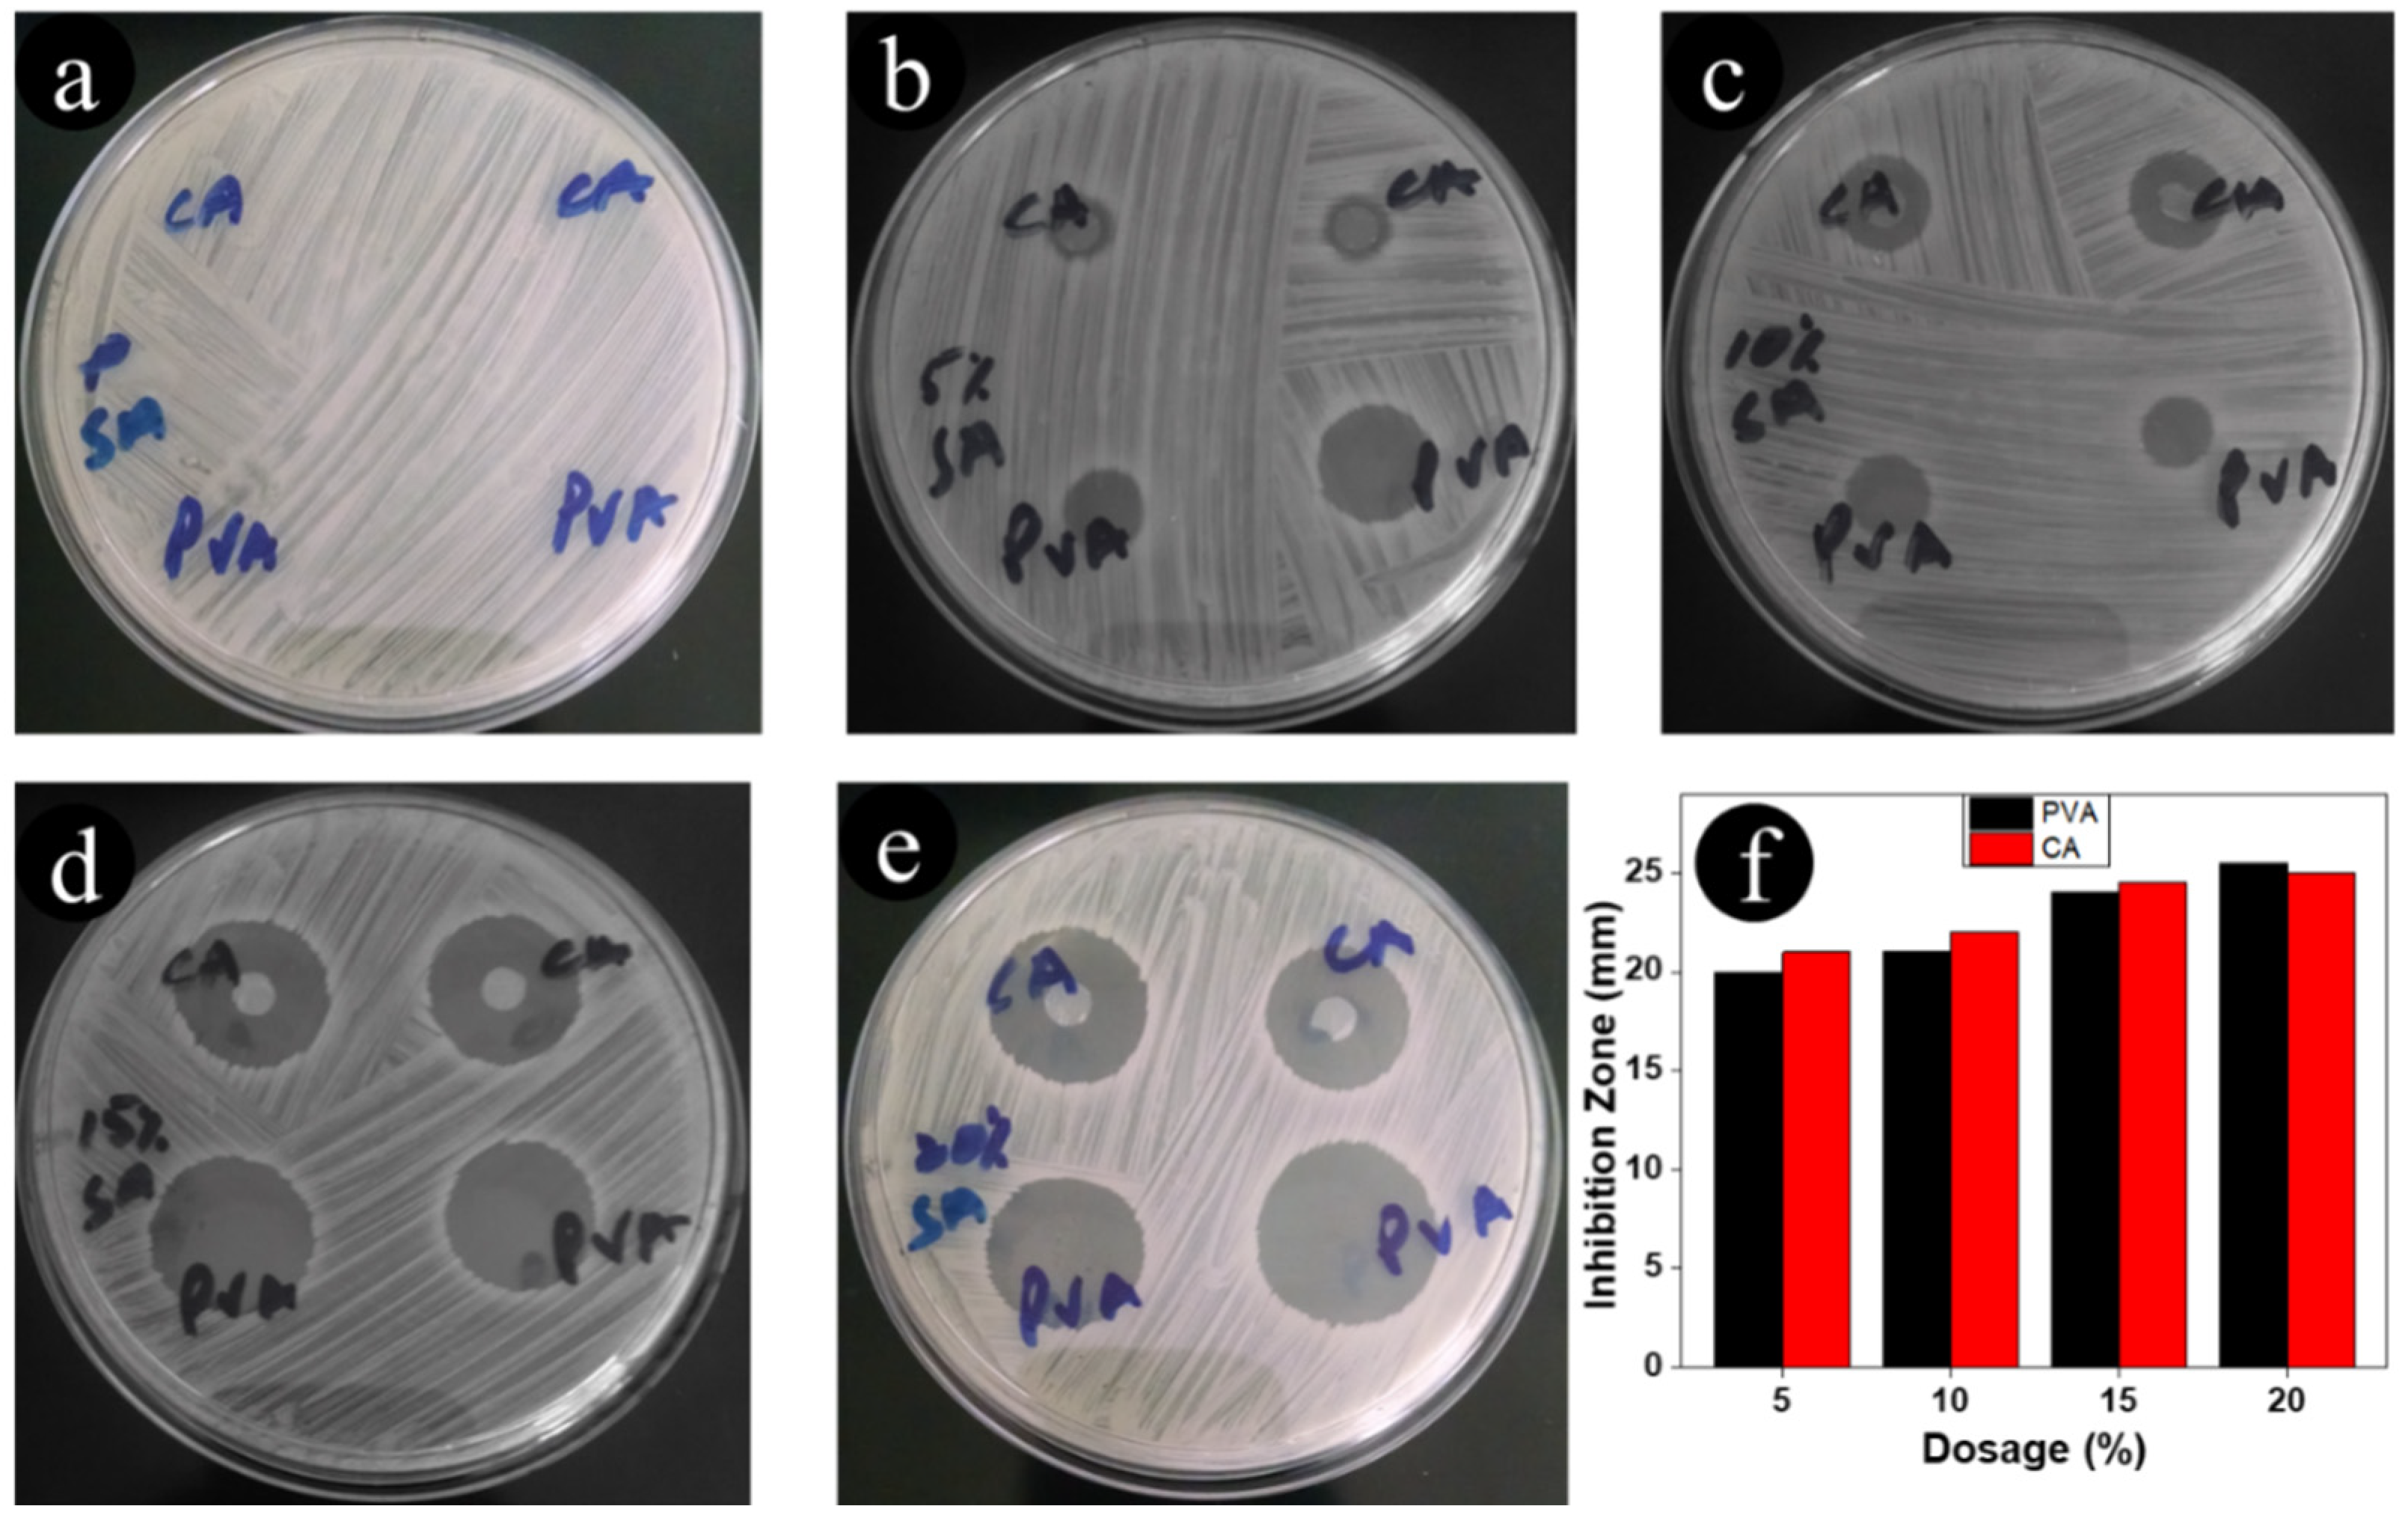
Antibiotics 11 00352 g005 550

Fabrication of Ceftriaxone-Loaded Cellulose Acetate and Polyvinyl Alcohol Nanofibers and Their Antibacterial Evaluation
Abstract
:1. Introduction
2. Experimental Procedure
2.1. Materials
2.2. Method
2.2.1. Preparation of Nanofibers
2.2.2. Antimicrobial Activity of Nanofibers
2.2.3. Material Characterization
3. Results and Discussion
3.1. Physical Morphology of Nanofibers
3.2. FTIR Spectra of Nanofibers
3.3. XRD Spectra of Nanofibers
3.4. Antimicrobial Assessment of Nanofibers
4. Conclusions
Author Contributions
Funding
Institutional Review Board Statement
Informed Consent Statement
Data Availability Statement
Acknowledgments
Conflicts of Interest
References
- Ackermann, M.; Verleden, S.E.; Kuehnel, M.; Haverich, A.; Welte, T.; Laenger, F.; Vanstapel, A.; Werlein, C.; Stark, H.; Tzankov, A.; et al. Pulmonary vascular endothelialitis, thrombosis, and angiogenesis in Covid-19. N. Engl. J. Med. 2020, 383, 120–128. [Google Scholar] [CrossRef] [PubMed]
- Hajipour, M.J.; Fromm, K.M.; Ashkarran, A.A.; de Aberasturi, D.J.; de Larramendi, I.R.; Rojo, T.; Serpooshan, V.; Parak, W.J.; Mahmoudi, M. Antibacterial properties of nanoparticles. Trends Biotechnol. 2012, 30, 499–511. [Google Scholar] [CrossRef] [PubMed] [Green Version]
- Cushnie, T.T.; Lamb, A.J. Recent advances in understanding the antibacterial properties of flavonoids. Int. J. Antimicrob. Agents 2011, 38, 99–107. [Google Scholar] [CrossRef] [PubMed]
- Iqbal, H.; Khan, B.A.; Khan, Z.U.; Razzaq, A.; Khan, N.U.; Menaa, B.; Menaa, F. Fabrication, physical characterizations and in vitro antibacterial activity of cefadroxil-loaded chitosan/poly (vinyl alcohol) nanofibers against Staphylococcus aureus clinical isolates. Int. J. Biol. Macromol. 2020, 144, 921–931. [Google Scholar] [CrossRef] [PubMed]
- Zeraati, M.; Pourmohamad, R.; Baghchi, B.; Chauhan NP, S.; Sargazi, G. Optimization and predictive modelling for the diameter of nylon-6, 6 nanofibers via electrospinning for coronavirus face masks. J. Saudi Chem. Soc. 2021, 25, 101348. [Google Scholar] [CrossRef]
- Sargazi, G.; Afzali, D.; Mostafavi, A.; Kazemian, H. A novel composite derived from a metal organic framework immobilized within electrospun nanofibrous polymers: An efficient methane adsorbent. Appl. Organomet. Chem. 2020, 34, e5448. [Google Scholar] [CrossRef]
- Naderi, N.; Agend, F.; Faridi-Majidi, R.; Sharifi-Sanjani, N.; Madani, M. Prediction of nanofiber diameter and optimization of electrospinning process via response surface methodology. J. Nanosci. Nanotechnol. 2008, 8, 2509–2515. [Google Scholar] [CrossRef]
- El-Ghazali, S.; Khatri, M.; Hussain, N.; Khatri, Z.; Yamamoto, T.; Kim, S.H.; Kobayashi, S.; Kim, I.S. Characterization and biocompatibility evaluation of artificial blood vessels prepared from pristine poly (Ethylene-glycol-co-1, 4-cyclohexane dimethylene-co-isosorbide terephthalate), poly (1, 4 cyclohexane di-methylene-co-isosorbide terephthalate) nanofibers and their blended composition. Mater. Today Commun. 2021, 26, 102113. [Google Scholar]
- Iqbal, H.; Mahar, F.K.; Razzaq, A.; Kamal, R.; Khan, N.U.; Ullah, K.; Iqbal, S. Green synthesis of Cefadroxil loaded chitosan/PVA nanofibers by freeze drying. Mater. Res. Express 2019, 6, 125094. [Google Scholar] [CrossRef]
- Dong, R.H.; Qin, C.C.; Qiu, X.; Yan, X.; Yu, M.; Cui, L.; Zhou, Y.; Zhang, H.D.; Jiang, X.Y.; Long, Y.Z. In situ precision electrospinning as an effective delivery technique for cyanoacrylate medical glue with high efficiency and low toxicity. Nanoscale 2015, 7, 19468–19475. [Google Scholar] [CrossRef]
- Wang, X.; Xiang, H.; Song, C.; Zhu, D.; Sui, J.; Liu, Q.; Long, Y. Highly efficient transparent air filter prepared by collecting-electrode-free bipolar electrospinning apparatus. J. Hazard. Mater. 2020, 385, 121535. [Google Scholar] [CrossRef] [PubMed]
- Wang, Y.Y.; Xu, F.Z.; Zhu, Y.Y.; Song, B.; Luo, D.; Yu, G.; Chen, S.; Xue, W.; Wu, J. Pyrazolo [3, 4-d] pyrimidine derivatives containing a Schiff base moiety as potential antiviral agents. Bioorg. Med. Chem. Lett. 2018, 28, 2979–2984. [Google Scholar] [CrossRef] [PubMed]
- Han, J.; Liu, Z.; Ma, Y.; Cui, G.; Xie, F.; Wang, F.; Wu, Y.; Gao, S.; Xu, Y.; Sun, X. Ambient N2 fixation to NH3 at ambient conditions: Using Nb2O5 nanofiber as a high-performance electrocatalyst. Nano Energy 2018, 52, 264–270. [Google Scholar] [CrossRef]
- Liao, Y.; Loh, C.H.; Tian, M.; Wang, R.; Fane, A.G. Progress in electrospun polymeric nanofibrous membranes for water treatment: Fabrication, modification and applications. Prog. Polym. Sci. 2018, 77, 69–94. [Google Scholar] [CrossRef]
- Zhang, Z.; El-Moghazy, A.Y.; Wisuthiphaet, N.; Nitin, N.; Castillo, D.; Murphy, B.G.; Sun, G. Daylight-induced antibacterial and antiviral nanofibrous membranes containing vitamin K derivatives for personal protective equipment. ACS Appl. Mater. Interfaces 2020, 12, 49416–49430. [Google Scholar] [CrossRef]
- Guo, S.; Yu, B.; Ahmed, A.; Cong, H.; Shen, Y. Synthesis of polyacrylonitrile/polytetrahydropyrimidine (PAN/PTHP) nanofibers with enhanced antibacterial and anti-viral activities for personal protective equipment. J. Hazard. Mater. 2022, 424, 127602. [Google Scholar] [CrossRef]
- Matysiak, W.; Tański, T.; Smok, W. Electrospinning as a versatile method of composite thin films fabrication for selected applications. In Solid State Phenomena; Trans Tech Publications Ltd.: Bach, Switzerland, 2019; Volume 293, pp. 35–49. [Google Scholar]
- Ulubayram, K.; Calamak, S.; Shahbazi, R.; Eroglu, I. Nanofibers based antibacterial drug design, delivery and applications. Curr. Pharm. Des. 2015, 21, 1930–1943. [Google Scholar] [CrossRef]
- Ashraf, R.; Sofi, H.S.; Akram, T.; Rather, H.A.; Abdal-hay, A.; Shabir, N.; Vasita, R.; Alrokayan, S.H.; Khan, H.A.; Sheikh, F.A. Fabrication of multifunctional cellulose/TiO2/Ag composite nanofibers scaffold with antibacterial and bioactivity properties for future tissue engineering applications. J. Biomed. Mater. Res. Part A 2020, 108, 947–962. [Google Scholar] [CrossRef]
- Ahire, J.J.; Hattingh, M.; Neveling, D.P.; Dicks, L.M. Copper-containing anti-biofilm nanofiber scaffolds as a wound dressing material. PLoS ONE 2016, 11, e0152755. [Google Scholar] [CrossRef] [Green Version]
- Malwal, D.; Gopinath, P. Efficient adsorption and antibacterial properties of electrospun CuO-ZnO composite nanofibers for water remediation. J. Hazard. Mater. 2017, 321, 611–621. [Google Scholar] [CrossRef]
- Ajmal, G.; Bonde, G.V.; Mittal, P.; Khan, G.; Pandey, V.K.; Bakade, B.V.; Mishra, B. Biomimetic PCL-gelatin based nanofibers loaded with ciprofloxacin hydrochloride and quercetin: A potential antibacterial and anti-oxidant dressing material for accelerated healing of a full thickness wound. Int. J. Pharm. 2019, 567, 118480. [Google Scholar] [CrossRef]
- Durham, S.H.; Wingler, M.J.; Eiland, L.S. Appropriate use of ceftriaxone in the emergency department of a Veteran’s health care system. J. Pharm. Technol. 2017, 33, 215–218. [Google Scholar] [CrossRef]
- Akbar, N.; Aslam, Z.; Siddiqui, R.; Shah, M.R.; Khan, N.A. Zinc oxide nanoparticles conjugated with clinically-approved medicines as potential antibacterial molecules. AMB Express 2021, 11, 104. [Google Scholar] [CrossRef] [PubMed]
- Harshiny, M.; Matheswaran, M.; Arthanareeswaran, G.; Kumaran, S.; Rajasree, S. Enhancement of antibacterial properties of silver nanoparticles–ceftriaxone conjugate through Mukiamaderaspatana leaf extract mediated synthesis. Ecotoxicol. Environ. Saf. 2015, 121, 135–141. [Google Scholar] [CrossRef] [PubMed]
- AbouElleef, E.M.; Mahrouka, M.M.; Salem, S.E. A Physical-Chemical Study of the Interference of Ceftriaxone Antibiotic with Copper Chloride Salt. Bioinorg. Chem. Appl. 2021, 2021, 4018843. [Google Scholar] [CrossRef] [PubMed]
- Manimekalai, P.; Dhanalakshmi, R.; Manavalan, R. Preparation and characterization of ceftriaxone sodium encapsulated chitosan nanoparticles. Int. J. Appl. Pharm. 2017, 9, 10–15. [Google Scholar] [CrossRef] [Green Version]
- Fatahian, R.; Mirjalili, M.; Khajavi, R.; Rahimi, M.K.; Nasirizadeh, N. Fabrication of antibacterial and hemostatic electrospun PVA nanofibers for wound healing. SN Appl. Sci. 2020, 2, 1288. [Google Scholar] [CrossRef]
- Sharaf, S.; El-Naggar, M.E. Eco-friendly technology for preparation, characterization and promotion of honeybee propolis extract loaded cellulose acetate nanofibers in medical domains. Cellulose 2018, 25, 5195–5204. [Google Scholar] [CrossRef]
- Alhosseini, S.N.; Moztarzadeh, F.; Mozafari, M.; Asgari, S.; Dodel, M.; Samadikuchaksaraei, A.; Kargozar, S.; Jalali, N. Synthesis and characterization of electrospun polyvinyl alcohol nanofibrous scaffolds modified by blending with chitosan for neural tissue engineering. Int. J. Nanomed. 2012, 7, 25. [Google Scholar]
- Gunasekaran, S.; Charles, J. Spectral measurements and qualitative analysis of ceftriaxone and cefotaxime. Asian J. Chem. 2008, 20, 1343. [Google Scholar]
- Ahmed, F.; Arbab, A.A.; Jatoi, A.W.; Khatri, M.; Memon, N.; Khatri, Z.; Kim, I.S. Ultrasonic-assisted deacetylation of cellulose acetate nanofibers: A rapid method to produce cellulose nanofibers. Ultrason. Sonochem. 2017, 36, 319–325. [Google Scholar] [CrossRef] [PubMed]
- Mushtaq, S.; Khan, J.A.; Rabbani, F.; Latif, U.; Arfan, M.; Yameen, M.A. Biocompatible biodegradable polymeric antibacterial nanoparticles for enhancing the effects of a third-generation cephalosporin against resistant bacteria. J. Med. Microbiol. 2017, 66, 318–327. [Google Scholar] [CrossRef] [PubMed]
- Patrojanasophon, P.; Tidjarat, S.; Opanasopit, P.; Ngawhirunpat, T.; Rojanarata, T. Influence of nanofiber alignment on the release of a water-soluble drug from cellulose acetate nanofibers. Saudi Pharm. J. 2020, 28, 1210–1216. [Google Scholar] [CrossRef] [PubMed]

Publisher’s Note: MDPI stays neutral with regard to jurisdictional claims in published maps and institutional affiliations. |
© 2022 by the authors. Licensee MDPI, Basel, Switzerland. This article is an open access article distributed under the terms and conditions of the Creative Commons Attribution (CC BY) license (https://creativecommons.org/licenses/by/4.0/).
Share and Cite
Youdhestar; Mahar, F.K.; Das, G.; Tajammul, A.; Ahmed, F.; Khatri, M.; Khan, S.; Khatri, Z. Fabrication of Ceftriaxone-Loaded Cellulose Acetate and Polyvinyl Alcohol Nanofibers and Their Antibacterial Evaluation. Antibiotics 2022, 11, 352. https://doi.org/10.3390/antibiotics11030352
Youdhestar, Mahar FK, Das G, Tajammul A, Ahmed F, Khatri M, Khan S, Khatri Z. Fabrication of Ceftriaxone-Loaded Cellulose Acetate and Polyvinyl Alcohol Nanofibers and Their Antibacterial Evaluation. Antibiotics. 2022; 11(3):352. https://doi.org/10.3390/antibiotics11030352
Chicago/Turabian StyleYoudhestar, Faraz Khan Mahar, Gotam Das, Ayesha Tajammul, Farooq Ahmed, Muzamil Khatri, Sheeraz Khan, and Zeeshan Khatri. 2022. "Fabrication of Ceftriaxone-Loaded Cellulose Acetate and Polyvinyl Alcohol Nanofibers and Their Antibacterial Evaluation" Antibiotics 11, no. 3: 352. https://doi.org/10.3390/antibiotics11030352
APA StyleYoudhestar, Mahar, F. K., Das, G., Tajammul, A., Ahmed, F., Khatri, M., Khan, S., & Khatri, Z. (2022). Fabrication of Ceftriaxone-Loaded Cellulose Acetate and Polyvinyl Alcohol Nanofibers and Their Antibacterial Evaluation. Antibiotics, 11(3), 352. https://doi.org/10.3390/antibiotics11030352

